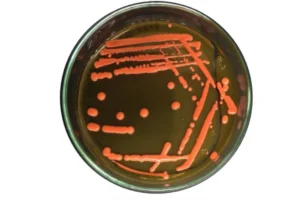

Lưu trữ Danh mục: Nhà Nông 24h – Tổng hợp tin tức, kỹ thuật
Tyramine trong thức ăn của tôm thẻ chân trắng
Sự giải phóng các amin sinh học là phản ứng chính đối với tình trạng
Những cách lựa chọn cá cảnh hợp phong thủy
Thú vui nuôi cá cảnh từ lâu đã rất phổ biến tại Việt Nam, đặc
Nấm men đỏ Rhodotorula mucilaginosa JM-01 – Loại nguyên liệu tiềm năng
Nấm men đỏ biển, được phân lập từ trầm tích biển và đường tiêu hóa
Bình Định: Phấn khởi khi tàu cá đầu tiên đã mang rác về bờ
Theo thông tin từ Ban Quản lý Cảng cá Bình Định cho biết, vào lúc
Vi sinh xử lý phèn có hiệu quả thật sự không?
Hiện tượng ao nuôi xuất hiện phèn xảy ra thường xuyên, đặc biệt là ở
Ổn định độ mặn cho ao nuôi
Độ mặn là một trong những yếu tố quan trọng ảnh hưởng đến sự sinh
Hội Thủy sản Việt Nam tổ chức Hội nghị Ban thường vụ mở rộng
Chiều 14/12/2023, Hội Thủy sản Việt Nam tổ chức Hội nghị Ban thường vụ mở
Bình Định: Thả 10.000 con cá chẽm giống xuống khu vực biển bãi Dứa xã Nhơn Lý
Sáng ngày 14.12, tại khu vực biển bãi Dứa, xã Nhơn Lý, Chi cục Thủy
Kiểm soát biến động pH nước ao nuôi
Ngoài việc kiểm soát chất lượng giống đầu vào, chất lượng thức ăn và quản
Các phụ phẩm từ nuôi trồng thủy sản có dấu ấn ra sao với sản xuất protein?
Với sự việc trội so với các nhà sản xuất protein khác trong việc đáp
Dầu tràm trà gây mê cho cá tra
Ngư nghiệp (nghề nuôi cá), cũng giống như bất kỳ hoạt động canh tác nào
Các yếu tố ảnh hưởng đến quá trình lột xác của tôm thẻ chân trắng
Trong nuôi tôm, quá trình lột xác diễn ra thường xuyên. Lột xác đóng vai